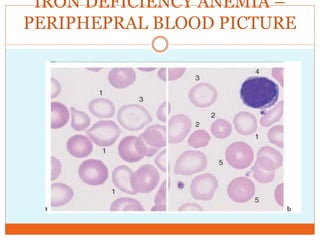
IRON DEFICIENCY ANEMIA –
PERIPHEPRAL BLOOD PICTURE

This document defines anemia and describes its causes and symptoms. Anemia is a reduction in red blood cells or hemoglobin below normal levels. It can be classified based on red blood cell morphology or etiology. Common causes include blood loss, red blood cell destruction, nutritional deficiencies, and bone marrow disorders. Symptoms result from reduced oxygen carrying capacity and include fatigue, paleness, weakness, and increased heart rate. Severe anemia places greater workload on the heart and can lead to cardiac failure during exercise due to extreme tissue hypoxia.